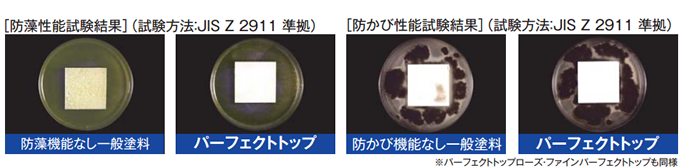

このパーフェクトトップは今非常に人気のある商品で金額もリーズナブルでありながら耐久性にも優れた塗料です!
今まではシリコン性の塗料が価格的にもリーズナブルで耐久性もフッ素樹脂塗料の次に良いとされて愛されてきました! しかしシリコン系塗料のその上をいく塗料を日本ペイントの最先端技術により完成されたのがラジカル制御技術を搭載したパーフェクトトップなのです!

紫外線による塗膜劣化対策として独自の 「ラジカル制御」技術に より、シリコングレードを超える(日本ペイント株式会社従来品比) 非常にすぐれた耐候性があります。 耐候性の実力は JIS A 6909耐候形1種に相当します。
促進耐候性試験で2500時間経過後、光沢保持率が80%である塗料が耐候形1種の高耐候性塗料となります。


ポリマーが塗膜間の隙間を埋めるため、緻密でなめらかな塗膜形成が可能となり、すぐれた高光沢を実現しました。 また、パーフェクトシリーズ下塗りと組み合わせることで美しい外観が得られます。ニーズに合わせたしっとりとした落ち着きのある3分つや、つや消しなどつやの調整も可能です。
上塗りの吸い込みの違いにより、光沢感が異なります。 ※写真の白い筋は塗膜凸面の光の反射によるものです。
低汚染性・防藻・防かび機能を標準で有しています。 親水化技術により低汚染性を発揮することで雨だれ汚染に対してすぐれた効果を発揮します。また、防藻・防かび機能でいやな藻やかび菌の発生を抑制します。オプションで強力防かびを選択することも可能です。